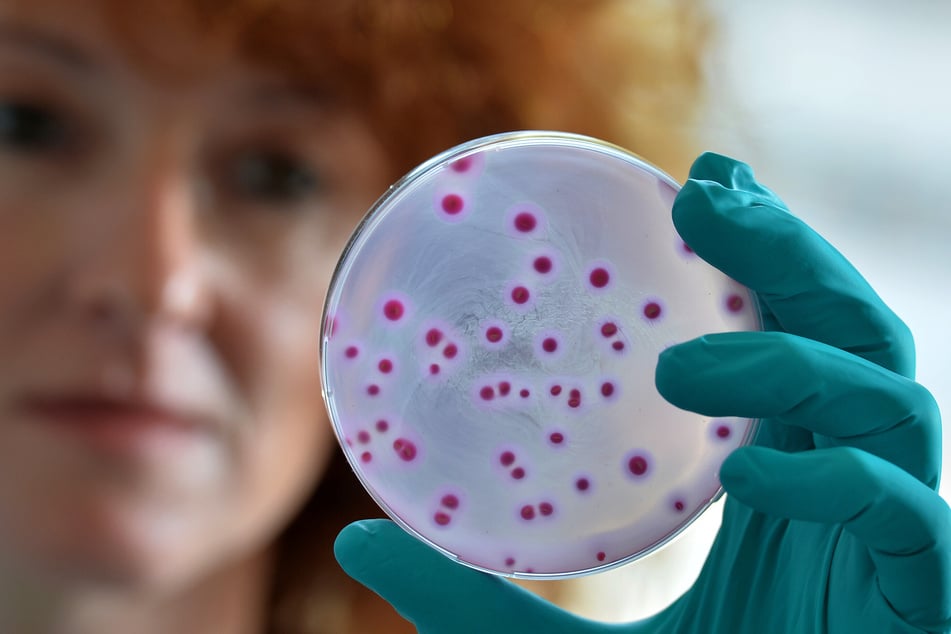
E.-coli- und Klebsiella-Bakterien sind bei Betroffenen besonders häufig. (Symbolfoto)

Torkeln ohne Alkohol? Forscher erklären kurioses Phänomen
San Diego (USA) - Nach Hause torkeln statt gehen, wenn aus einem Feierabendbier zehn geworden sind? Logisch. Manche Menschen aber brauchen gar keinen Alkohol, um betrunken zu sein ...

Sie brauen den Alkohol in ihrem Darm schlichtweg selbst! Nach dem Konsum von Kohlenhydraten machen sich bestimmte, ethanolproduzierende Darmbakterien ans Werk.
Darauf deuten die Ergebnisse der bislang größten Studie über das seit dem 19. Jahrhundert bekannte "Eigenbrauer-Syndrom" hin, über die Science berichtet.
"Diese Krankheit ist für Familien furchtbar. Den Patienten wird nicht geglaubt", erklärt Studienleiter Bernd Schnabl von der University of California in San Diego gegenüber dem Magazin.
Seine Studie bestätigt einen Verdacht, den Forscher erst seit wenigen Jahren haben - dass höchstwahrscheinlich Bakterien statt Hefepilze Grund für die ungewöhnliche Darmaktivität sind.
Eine extrem seltene Krankheit
Sie untersuchten den Stuhl von 22 Patienten und fanden erhöhte Konzentrationen von Klebsiella- und E.-coli-Bakterien darin, aber nicht mehr Hefepilze als bei gesunden Kontrollpersonen.
Trotzdem können Pilze als mögliche Ursache nicht völlig ausgeschlossen werden, betont Bernd Schnabl.
Durchgeführt wurde die Studie mit 22 erkrankten Personen. Klingt nach wenig - doch weltweit sind eben auch extrem wenige Fälle des Eigenbrauer-Syndroms nachgewiesen.
Zugleich ist eine hohe Dunkelziffer wahrscheinlich - weil Leidtragende mit Trunkenheitsbeschwerden nicht immer ernst genommen werden.
Titelfoto: picture alliance/dpa | Robert Michael

